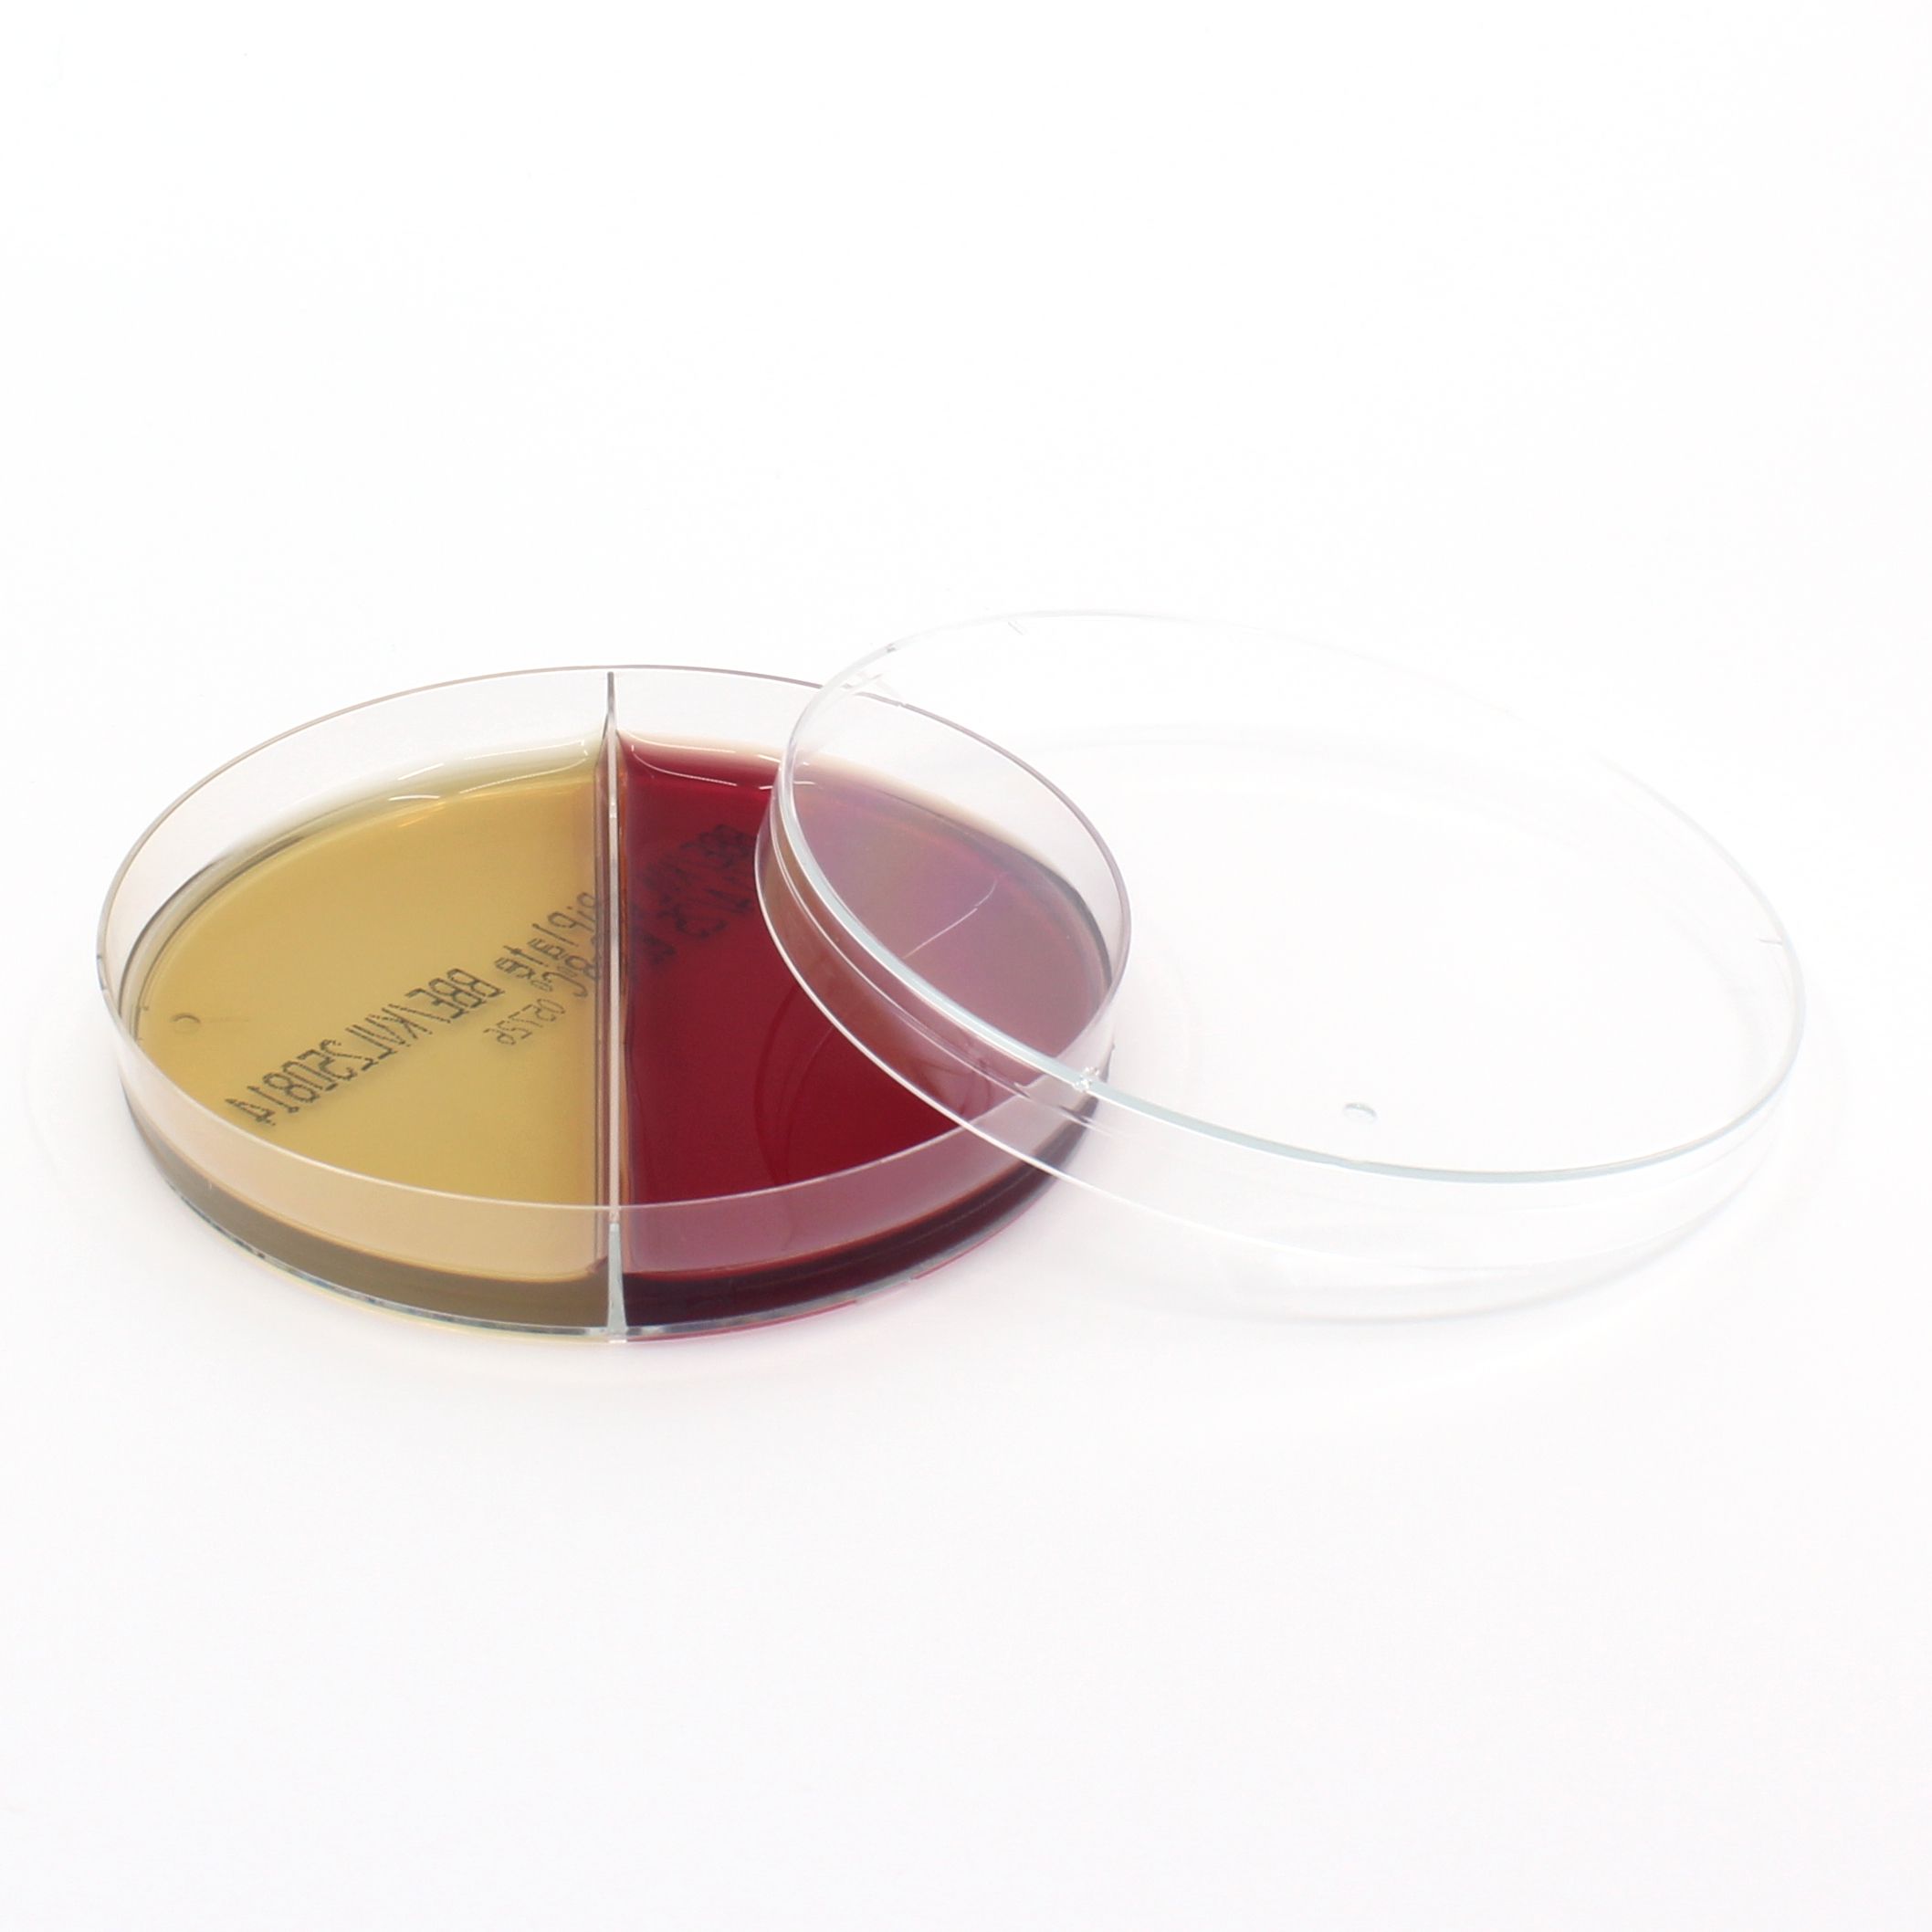
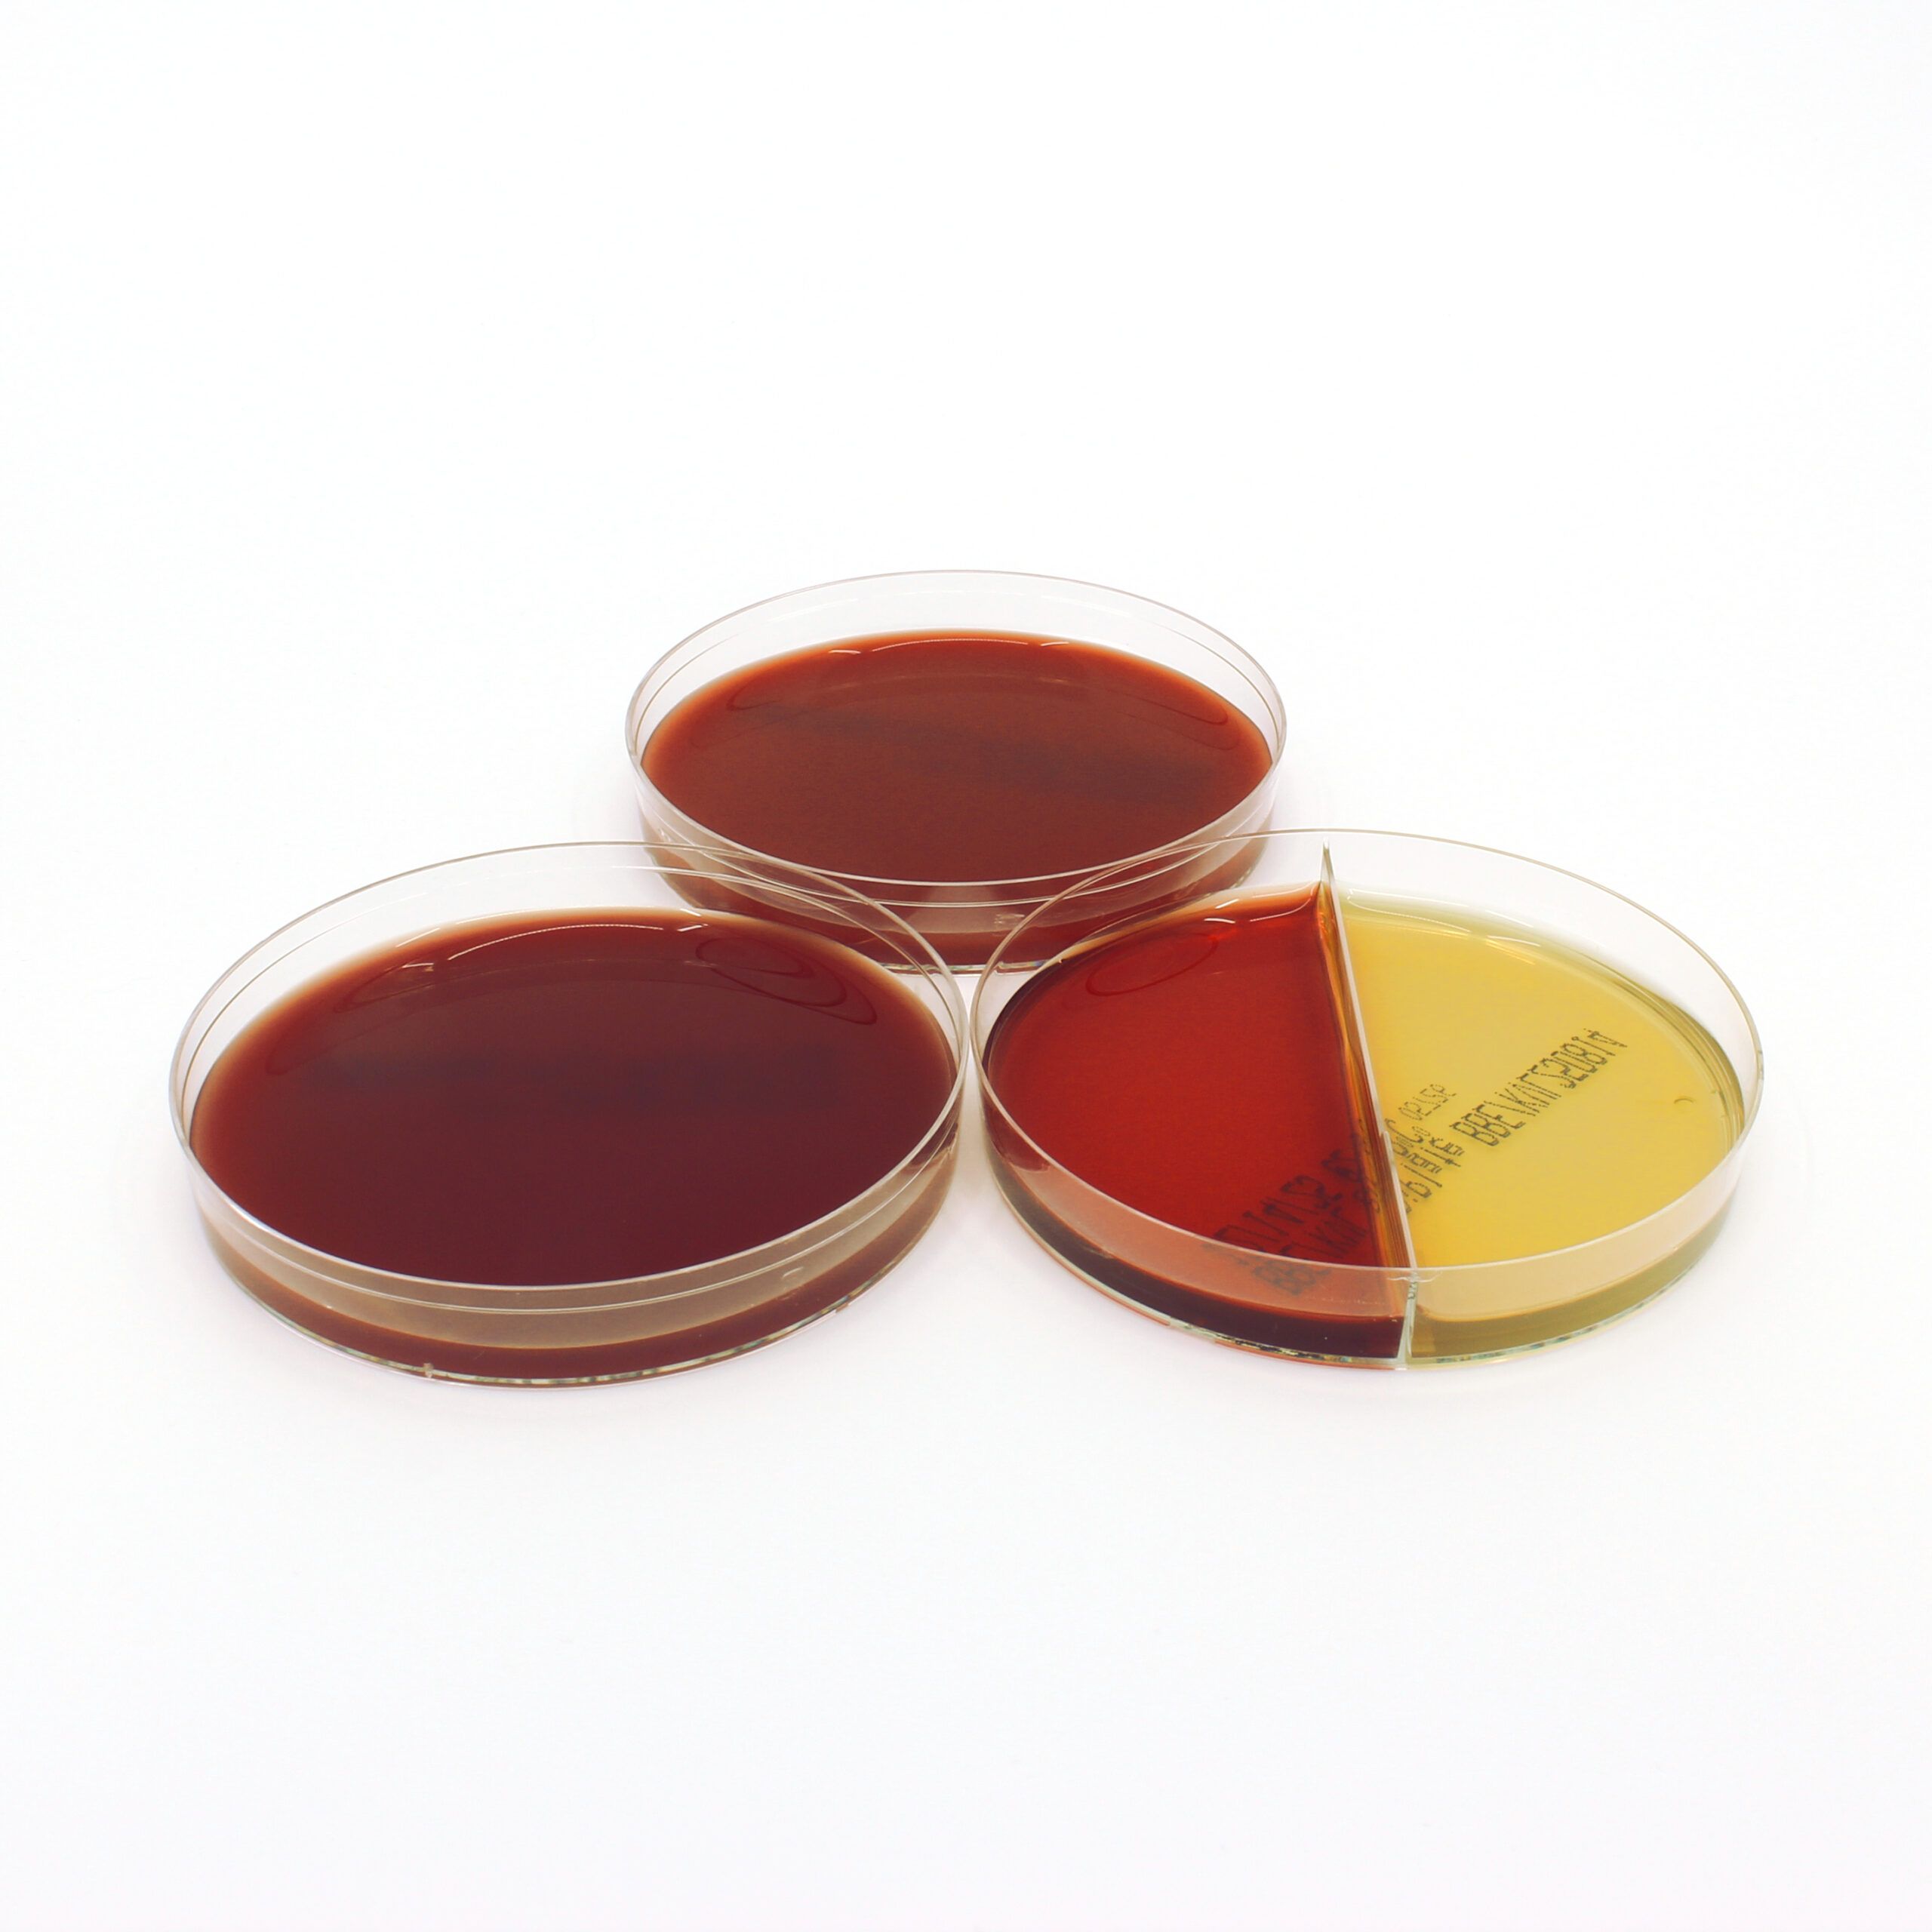
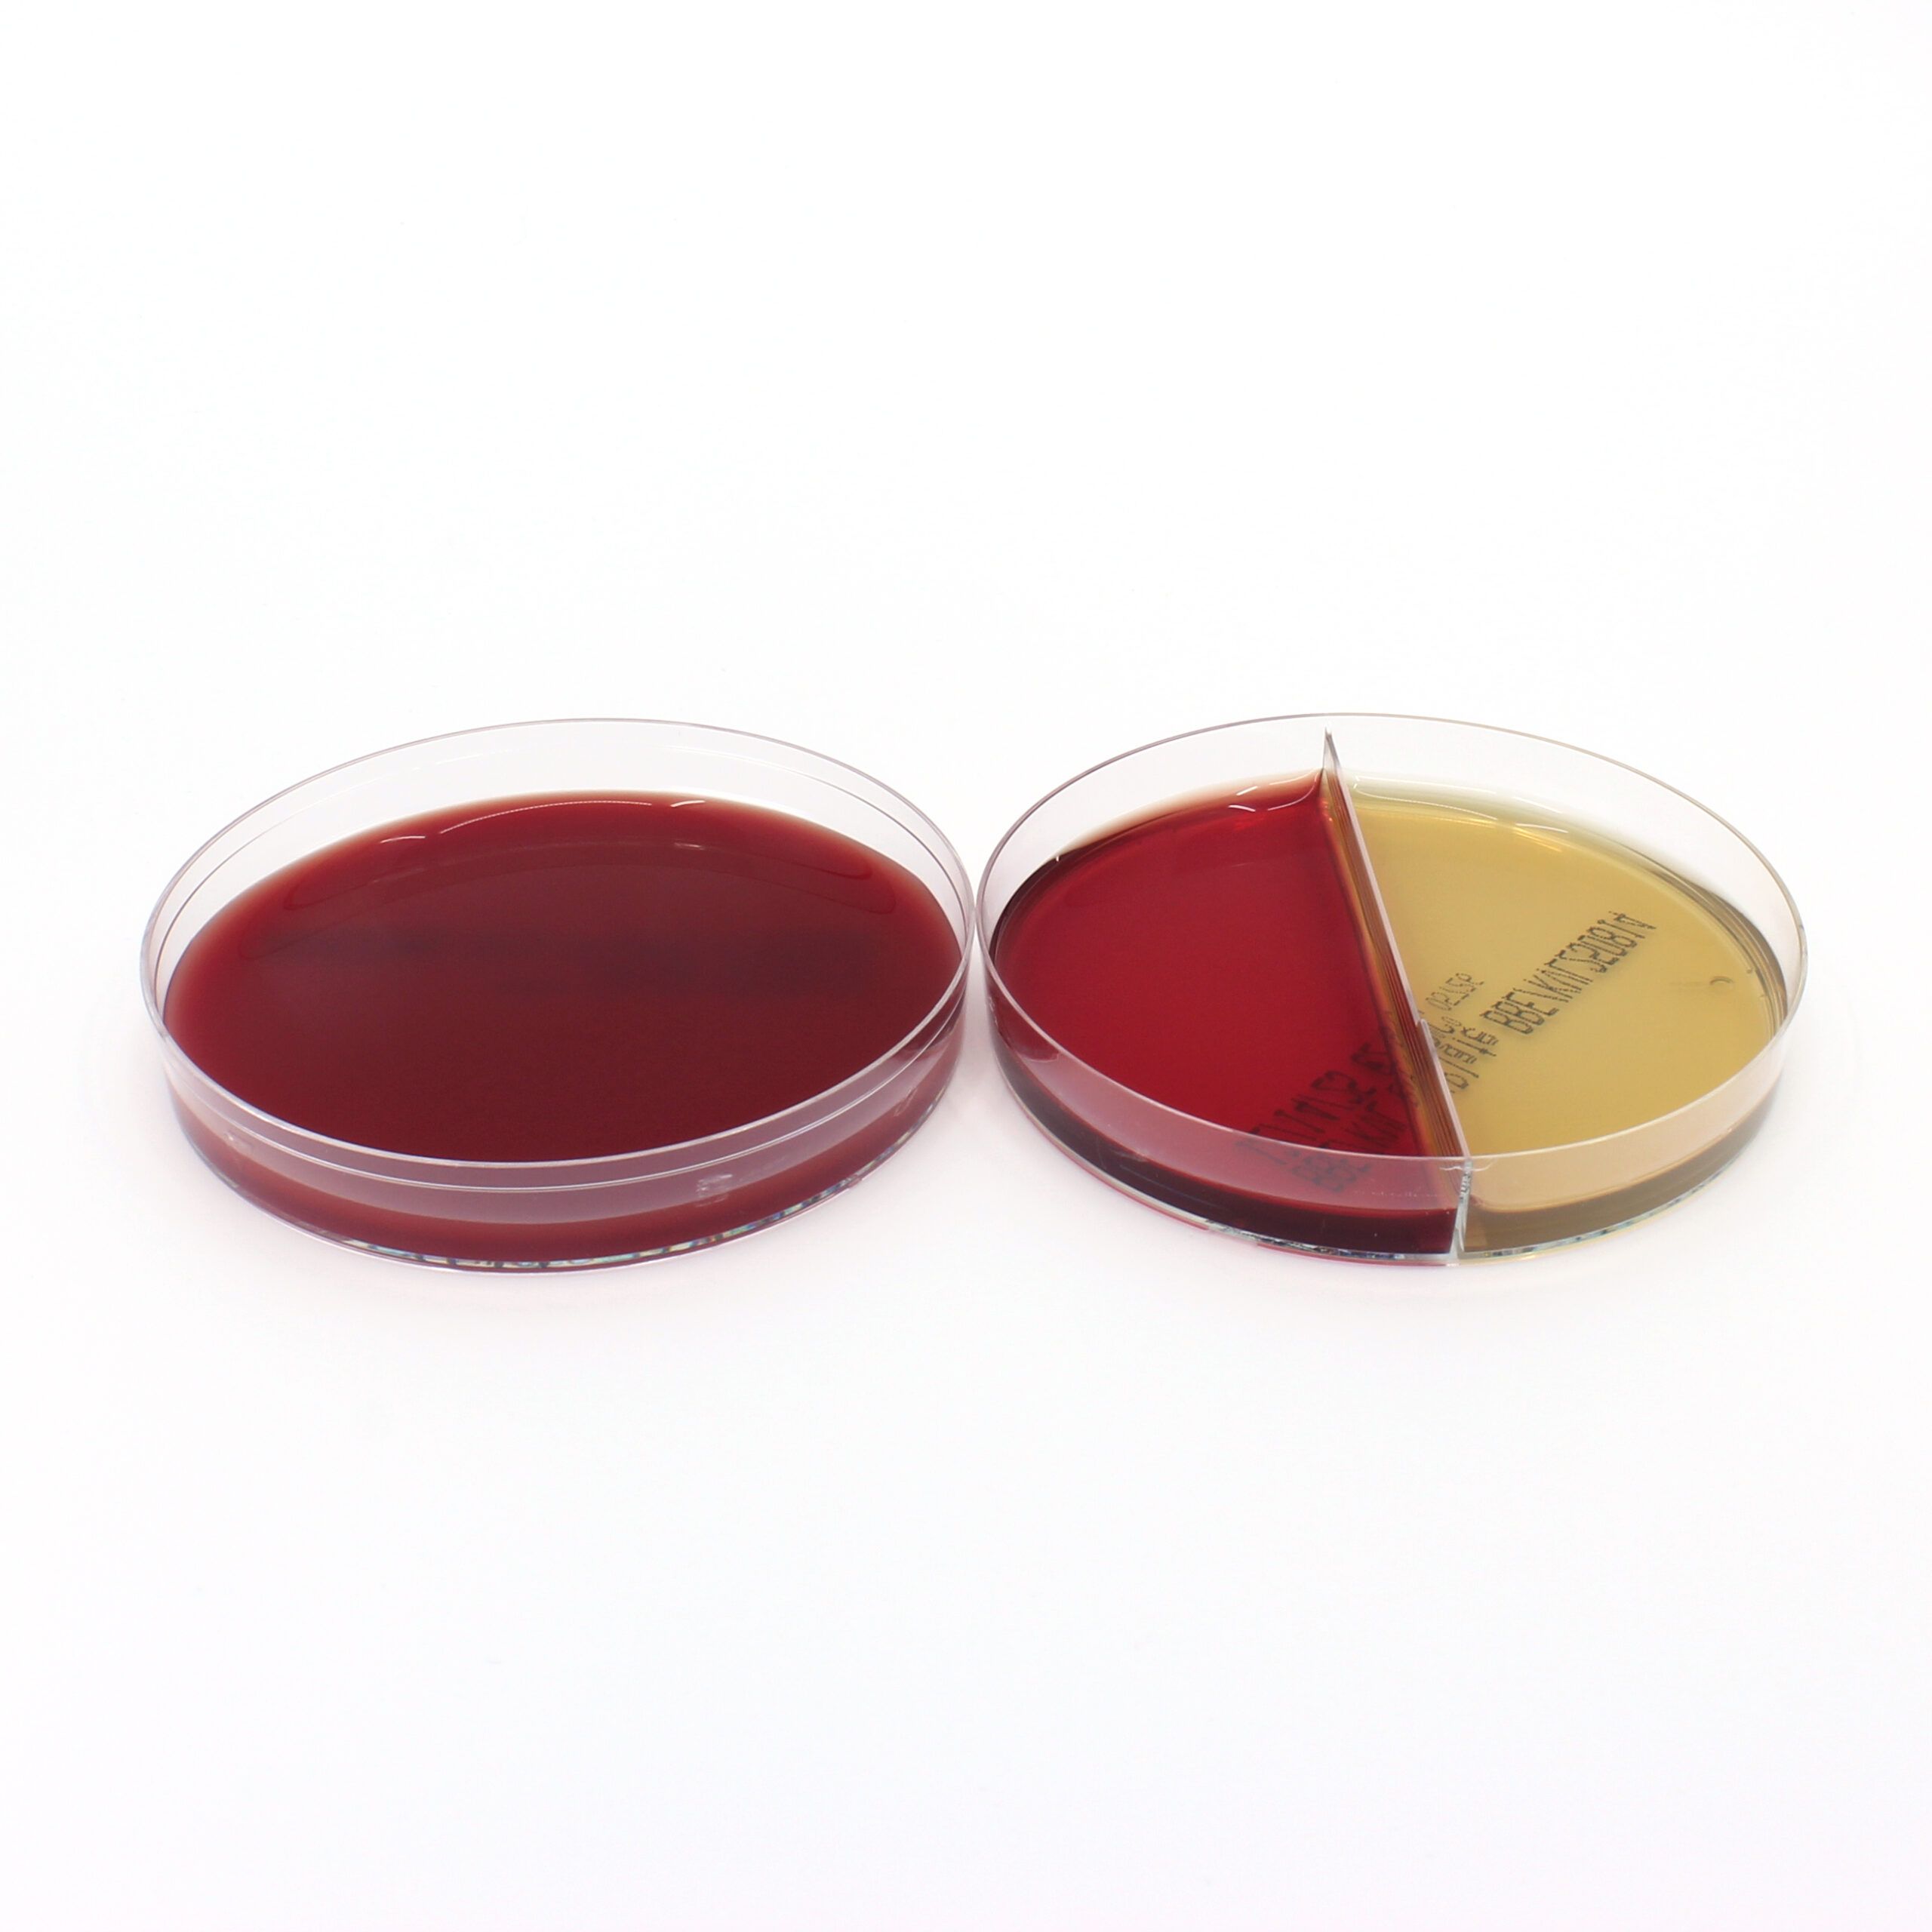
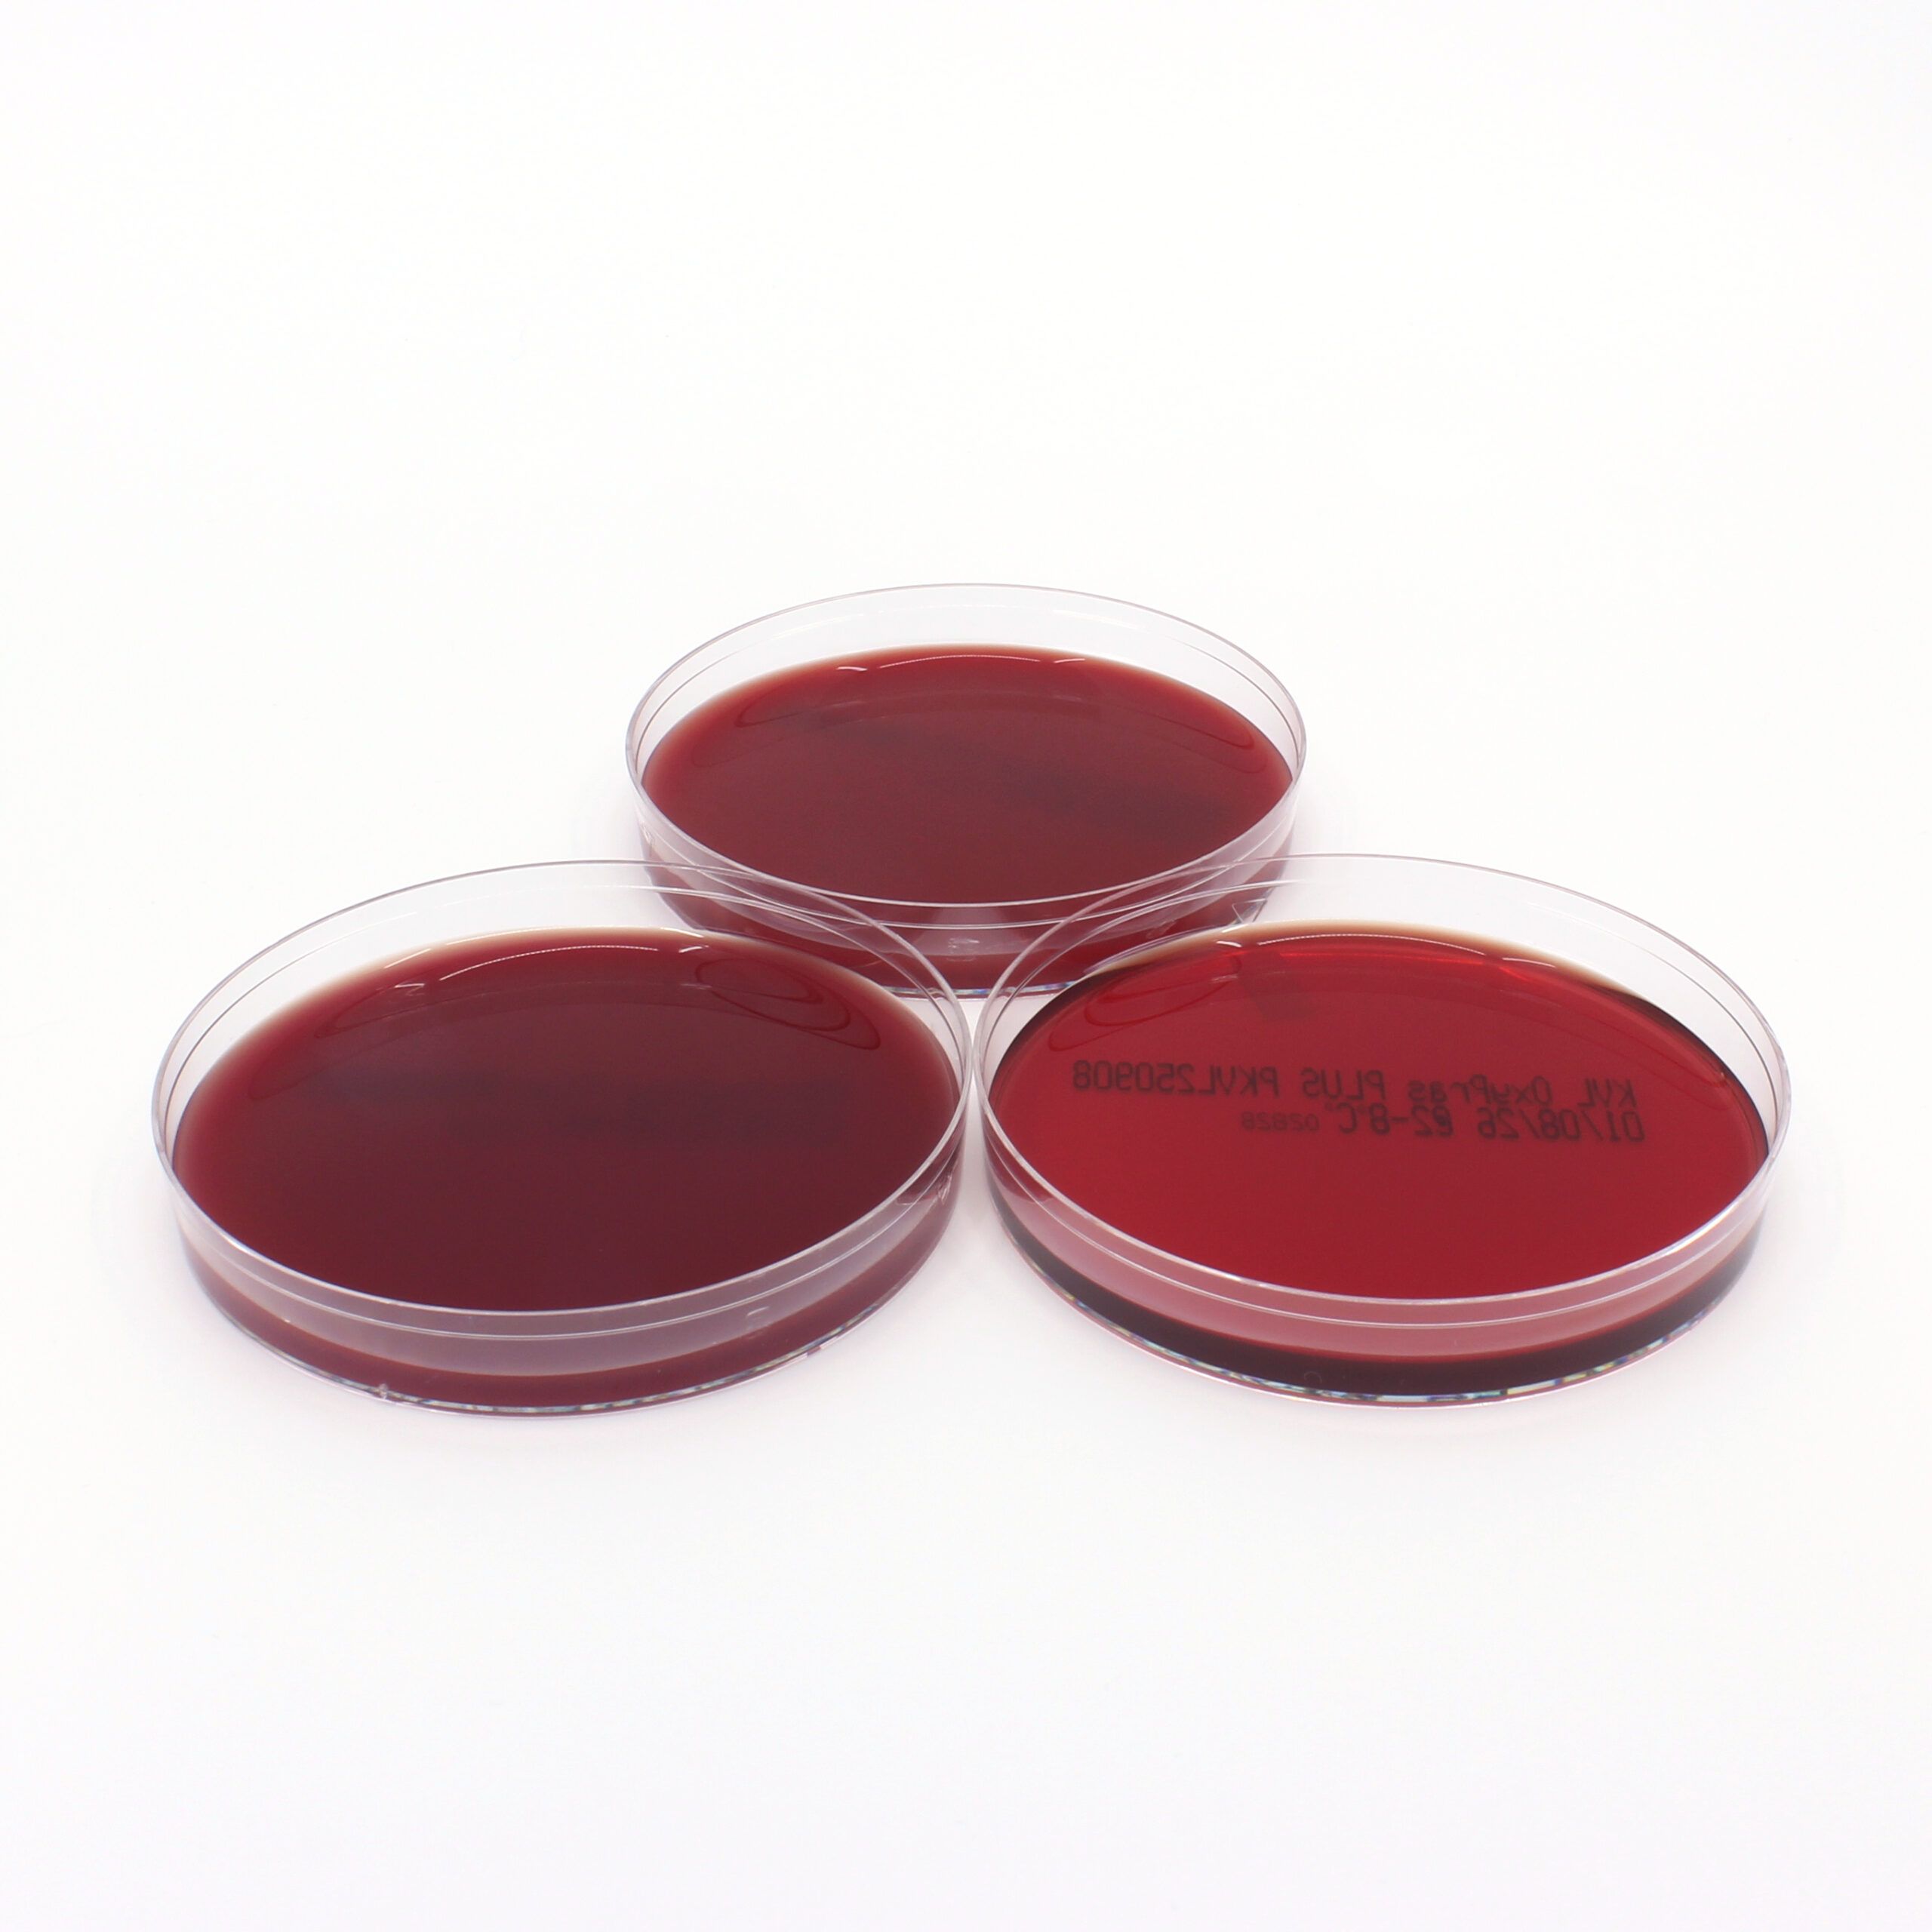

Our Products
EC-Oxyrase®
Oxyrase® Enzyme System, sterile, 30 u/mL
$94.88 – $3,749.36
EC-Oxyrase® is a sterile, enzyme-based oxygen removal system with consistent activity, effective across a broad pH and temperature range, and designed to rapidly reduce dissolved oxygen when used with a suitable substrate.
OxyBlue™ Indicator
OxyBlue™ Anaerobic Indicator
$14.08
OxyBlue is a simple, low-cost anaerobic indicator. One drop shows a blue-to-white color change when your plate or container reaches anaerobiosis.
OxyDish™
OxyDish™
$126.11
The OxyDish™ is a compact, single-use culture dish that creates and maintains an anaerobic environment for growing anaerobic microorganisms without the need for traditional jars, bags, or chambers, simplifying microbiological workflows and improving efficiency.
OxyFluor™
OxyFluor™
$81.46 – $5,638.69
OxyFluor™ uses the Oxyrase® Enzyme System to remove dissolved oxygen and reduce oxygen free radicals during fluorescent microscopy, enhancing fluorescence brightness and duration while protecting biological samples from photodamage.
Oxygen Adsorbers
Oxygen Adsorbers
$30.80
The Oxygen Adsorber removes oxygen inside the pouch, preserving Oxyrase activity for its role in keeping the medium reduced and performing during shelf life of the plate
OxyPack
OxyPack
$323.52
The OxyPak is a comprehensive kit that includes Oxyrase® for Broth, Oxyrase® for Agar, and OxyDishes™ for users seeking a complete solution for cultivating anaerobes.
OxyPRAS® Brain-Heart Infusion (BHI) Broth
OxyPRAS® BHI Broth with Hemin and Vitamin K
$148.70
OxyPRAS® BHI Broth is a pre-reduced, anaerobically sterilized, nutrient-rich medium enhanced with cysteine, Vitamin K₁, and Hemin for optimal growth of fastidious anaerobes without interfering with gram stain interpretation.
Oxyrase® for Agar
Oxyrase® for Agar
$69.16 – $121.81
Oxyrase® for Agar (OA) is a sterile enzyme formulation that utilizes the Oxyrase® Enzyme System to produce anaerobic conditions in your custom agar. Oxyrase® For Agar and the OxyDish™ make isolating and growing anaerobes straight forward. You benefit by saving time and money through increased efficiency eliminating the need for bags, chamber or jars.
Oxyrase® for Broth
Oxyrase® for Broth
$69.16 – $123.41
Oxyrase for Broth™ is a convenient supplement that instantly creates an anaerobic environment in broth media with just one drop per milliliter, eliminating the need for boiling.
OxyStab™
OxyStab™
$85.56
OxyStab™ is a solid, nutritionally enriched PRAS medium containing the Oxyrase® Enzyme System, designed for convenient storage and sharing of bacterial isolates in laboratory settings.
OxyStasis™
OxyStasis™
$32.80
OxyStasis™ is a liquid preservation medium that uses cryoprotectants and the Oxyrase® Enzyme System to prevent ice formation and oxidation, enabling long-term storage of biological materials in standard freezers without cellular damage.
OxyPlates™
PEA Blood Agar OxyPlate™
$4.47
OxyPlates™ are prepoured, PRAS agar plates that generate their own anaerobic environment using Oxyrase®, offering a convenient, reusable alternative to traditional anaerobic methods without the need for specialized equipment.
Schaedler Blood Agar OxyPlate™
$4.47
OxyPlates™ are prepoured, PRAS agar plates that generate their own anaerobic environment using Oxyrase®, offering a convenient, reusable alternative to traditional anaerobic methods without the need for specialized equipment.
KVL Blood Agar OxyPlate™
$4.47
OxyPlates™ are prepoured, ready-to-use anaerobic culture plates that simplify anaerobe cultivation by generating their own anaerobic environment without the need for traditional equipment like jars or chambers.
OxyPRAS Plus® Individual Plates
OxyPRAS Plus® StrictAna Blood Agar Plate
$2.80
The OxyPRAS™ Plate is a pre-reduced, anaerobically sterilized culture plate enhanced with the Oxyrase® Enzyme System to maintain a reduced state, offering superior performance and shelf life compared to conventional PRAS plates for isolating anaerobes from clinical specimens.
OxyPRAS Plus® PEA Blood Agar Plate
$2.80 – $26.69
The OxyPRAS™ Plate is a pre-reduced, anaerobically sterilized culture plate enhanced with the Oxyrase® Enzyme System to maintain a reduced state, offering superior performance and shelf life compared to conventional PRAS plates for isolating anaerobes from clinical specimens.
OxyPRAS Plus® KVL Blood Agar Plate
$2.80 – $26.69
The OxyPRAS™ Plate is a pre-reduced, anaerobically sterilized culture plate enhanced with the Oxyrase® Enzyme System to maintain a reduced state, offering superior performance and shelf life compared to conventional PRAS plates for isolating anaerobes from clinical specimens.
OxyPRAS Plus® Brucella Blood Agar Plate
$2.80 – $26.60
The OxyPRAS™ Plate is a pre-reduced, anaerobically sterilized culture plate enhanced with the Oxyrase® Enzyme System to maintain a reduced state, offering superior performance and shelf life compared to conventional PRAS plates for isolating anaerobes from clinical specimens.
OxyPRAS Plus® BBE Agar Plate
$2.80 – $26.69
The OxyPRAS™ Plate is a pre-reduced, anaerobically sterilized culture plate enhanced with the Oxyrase® Enzyme System to maintain a reduced state, offering superior performance and shelf life compared to conventional PRAS plates for isolating anaerobes from clinical specimens.
Modified Columbia Agar Plate
$31.83
The OxyPRAS™ Plate is a pre-reduced, anaerobically sterilized culture plate enhanced with the Oxyrase® Enzyme System to prevent oxidation, remain reduced in air, and provide superior performance and shelf life for isolating clinical anaerobes.
OxyPRAS Plus® BBE/KVL Bi-Plate
$3.06 – $30.53
The OxyPRAS™ Plate is a pre-reduced, ready-to-use anaerobic culture plate enhanced with the Oxyrase® Enzyme System to prevent oxidation, extend shelf life, and improve performance over conventional PRAS plates for isolating anaerobes from clinical specimens.
OxyPRAS Plus® Multi-Packs
OxyPRAS Plus® 3-pack: Brucella, PEA and BBE/KVL Bi-Plate
$102.74
The OxyPRAS Plus® Plate (Pre-Reduced Anaerobically Sterilized) is different from conventionally made PRAS plates due to the Oxyrase® Enzyme System.
OxyPRAS Plus® 2-Pack: Brucella and BBE/KVL Bi-Plate
$68.18
The OxyPRAS Plus® Plate (Pre-Reduced Anaerobically Sterilized) is different from conventionally made PRAS plates due to the Oxyrase® Enzyme System.
OxyPRAS Plus® 3-pack: Brucella, PEA and KVL
$102.74
Oxyrase® used during the manufacture of the plate prevents oxidation during its preparation. Oxyrase® is again added to the final plate. Oxyrase® keeps the plate reduced and confers properties to the OxyPRAS Plus® plate not found in standard or conventional PRAS plates. PRAS plates are needed to isolate all Anaerobes from clinical specimens.